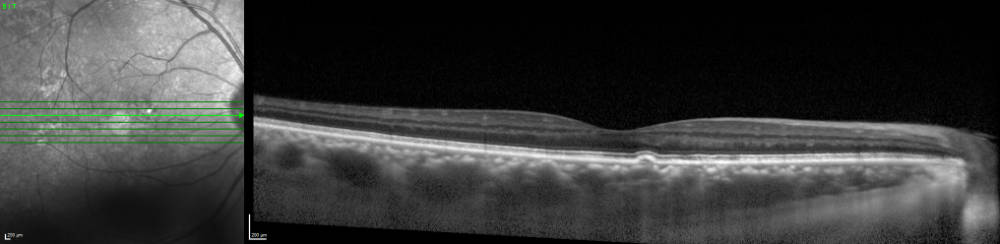

A method of performing and interpreting the retinal vasculature and macular findings so that a specific diagnosis and treatment could be entertained. It led to the development of a book entitled, “Interpretation of Fundus Fluorescein Angiography” by Louis C. Mosby, several years later.
Schatz H, Burton T, Yannuzzi LA, Rabb M: Interpretation of Fundus Fluorescein Angiography: A Comprehensive Text and Atlas. St. Louis, C. Mosby Co., 1978, 750 pages.

A variety of clinical features and imaging characteristics in central serous chorioretinopathy were reviewed and assembled in this report.
Peripheral retinal detachments and retinal pigment epithelial atrophic tracts secondary to central serous pigment epitheliopathy. Ophthalmol 91 (12):1554-1572, December 1984.

Type A Behavior in an individual who is identified as a precursor of central serous chorioretinopathy with endogenous stimulation of mineral corticosteroids and catacholamines.
Type A behavior and central serous chorioretinopathy. RETINA 7(2):111-131, 1987.

Yannuzzi LA, Sorenson J, Spaide RF, Lipson B
Idiopathic polypoidalchoroidalvasculopathy.RETINA 10:1-8, 1990.

Introduction of ICG angiography was a major accomplishment, which was possible only through the assimilation of digital imaging and the use of a fluorescent green dye of longer wavelength to image the choroidal circulation.
Guyer D, Yannuzzi L, Slakter J, Sorenson J, Orlock D.
The Status of Indocyanine-green videoangiography. Current Opinion in Ophthalmology 4:III;3-6, 1993.

Polypoidalchoroidal neovascularization pertained to a new vascular abnormality identified in the choroid with a particular predilection for people of color, including African-Americans and Asian people. It also affected Caucasians with a separate set of risk factors, clinical manifestations, imaging characteristics, and treatments.
Yannuzzi LA, Wong D, Scassellati-Sforzolini B, et al. PolypoidalChoroidalVasculopathy and Neovascularized Age-Related Macular Degeneration. Arch Ophthalmol 117: 1503-1510, 1999

Retinal angiomatous proliferation was a major accomplishment supported by The Macula Foundation, which Identified neovascularization which originated in the retina and became known eventually as Type 3 neovascularization in age-related macular degeneration. Also, it was referred to as Retinal Angiomatous Proliferation or RAP.
Yannuzzi LA, Negrao S, Iida T,Carvalho C, Rodriguez-Coleman H, Slakter JS, Freund KB, Sorenson J, Orlock D, Borodoker N.
Retinal angiomatous proliferation in age-related macular degeneration.RETINA 21:416-434, 2001.


Ciardella A, Borodoker N, Costa D, Huang S, Donsoff I, Yannuzzi L
The expanding clinical spectrum of central serous chorio-retinopathy. Comprehensive Ophthalmology Update 4(2):71-84,2003.

Macula Foundation investigators re-classified Idiopathic Macular Telangiectasia Type 1 and Type 2 in an updated version based on its clinical characteristics and angiographic features.
Idiopathic macular telangiectasia. Arch Ophthalmol 124:450-460, April 2006.

The nature of placoid pigment epitheliopathy was the discovery of a new disease supported by the Foundation, distinguishing it from similar infectious/inflammatory disorders.
Golchet P, Jampol L, Wilson D, Yannuzzi L, Ober M, Stroh E
Persistent placoidmaculopathy: a new clinical entity. Ophthalmology 114:1530-1540, 2007.

Zweifel SA, Engelbert M, Laud K, Margolis R, Spaide RF, Freund KB. Outer retinal tubulation: a novel optical coherence tomography finding. Arch Ophthalmol. 2009;127:1596-602.

The identification of subretinaldrusenoid deposits or reticular pseudo drusen was described in a paper on its nature and imaging characteristics. This is a major form of age-related macular degeneration.
Zweifel SA, Spaide RF, Yannuzzi LA. Acquired vitelliform detachment in patients with sub retinal
drusenoid deposit (reticular pseudodrusen). RETINA 31(2):229-34, 2011.

Focal Retinal Phlebitis described a new but uncommon, obstruction of the retinal venous system from a focal inflammation.
Hoang QV, Freund KB, Klancnik JM Jr, Sorenson JA, Cunningham ET Jr, Yannuzzi LA.
Focal retinal phlebitis. RETINA 32(1):120-126, 2012.


Acute Zonal Occult Outer Retinopathy described a rare inflammatory disorder of the retina. It clarified confusion with other inflammatory and infectious diseases.
Mrejen S, Kahn S, Gallego-Pinazzo R, Jampol L, Yannuzzi LA.
Acute Zonal Occult Outer Retinopathy: A Classification Based On Multimodal Imaging. JAMA Ophthalmol 132(9):1089-1098, 2014

Histologic and Optical Coherence Tomographic Correlates in Drusenoid Pigment Epithelium Detachment in Age-Related Macular Degeneration.
Balaratnasingam C, Messinger JD, Sloan KR, Yannuzzi LA, Freund KB, Curcio CA.
Ophthalmology. 2017 May;124(5):644-656. doi: 10.1016/j.ophtha.2016.12.034. Epub 2017 Jan 30.

Balaratnasingam C, Cherepanoff S, Dolz-Marco R, Killingsworth M, Chen F, Mendis R, Freund KB, Yannuzzi L. CuticularDrusen: Clinical Phenotypes and Natural History Defined Using Multimodal Imaging. Ophthalmology doi:10/1016/j.ophtha.2017.08.33 [Epub ahead of print], September 27, 2017.

Pseudoxanthoma Elasticaum or PSXE is a systemic disease that affects the mesodermal tissues of the body. Any organ that has elastic tissue may develop degenerative abnormalities from Elastin Degeneration and Calcific Deposition. In the eye, the macula becomes associated with angiod –like streaks and atrophic as well as neovascularized degeneration similar to AMD.
Lebwohl M, DiStefano D, Prioleau P, Uram M, Yannuzzi LA, Fleischmajer R, Pseudoxanthoma elasticum and mitral valve prolapse. New Eng J Med, 307 (4):228-231, 1982.

A study on the frequency of aphakic cystoid macular edema with new nonsteroidal anti-inflammatory drug. This was the first formulated, non-steroid anti-inflammatory medication, which was not a steroid. A number of other non-steroid drops have emerged since over the next years.
Lebwohl M, DiStefano D, Prioleau P, Uram M, Yannuzzi LA, Fleischmajer R, Pseudoxanthoma elasticum and mitral valve prolapse. New Eng J Med, 307 (4):228-231, 1982.

Studied the nature and pathogenesis of acute macular thermal events, which were the result of light exposure.
Yannuzzi LA, Fisher Y, Krueger A, Slakter J
Solar retinopathy: A photobiological and geophysical analysis.RETINA 9:28-43,1989.

Yannuzzi L, Jampol L, Rabb M, Sorenson J, Beyrer C, Wilcox L.
Unilateral acute idiopathic maculopathy.Arch Ophthalmol 109:1411-1416, 1991.

Digital Idocyanine-green Videoangiography of Occult Choroidal Neovascularization
Guyer D, Yannuzzi L, Slakter J, Sorenson J, Hope-Ross M, Orlock D
Ophthalmol 101(10): 1727-1737, 1994

Idiopathic ampigenous was the identification of a disease which combined the inflammatory/infectious nature of two known and better described abnormalities
Jones BE, Jampol LM, Yannuzzi LA, Tittl M, Johnson M, et al.
Relentless PlacoidChorioretinitis. A New Entity or an Unusual Variant of Serpigineous Chorioretinitis, Arch Ophthalmol 118:931-938, 2000.

The development of anti-VEGF medication for the treatment of wet degeneration was supported in several aspects by The Macula Foundation investigators (who tested the first drug, Macugen) and assisted at the level of the FDA in obtaining the approval for intraocular injections into the vitreous.
Yannuzzi and Eye Tech Study Group
Preclinical and phase 1A clinical evaluation of an Anti-VEGF pegylatedaptamer (EYE001) for the treatment of exudative age-related macular degeneration. RETINA 22:143-152, 2002.

The use of indocyanine-green was applied to the treatment of a permeable choroidal circulation in central serous chorioretinopathy with photodynamic therapy.
Yannuzzi LA, Slakter JS, Gross NE, Spaide RF, Costa D, Huang S,Klancnik J, Aizman A. Indocyanine green angiography-guided photodynamic therapy for treatment of chronic central serous chorioretinopathy. A Pilot Study. RETINA 23:288-298, 2003.

The expanded evanescent white dot syndrome is a rare unilateral disease which is immune-mediated in people with genetic predispositions.
Gross N, Yannuzzi L, Freund KB, Spaide R, Amato GP, Sigal R
Multiple Evanescent White Dot Syndrome. Arch Ophthalmol 124: 493-500, April 2006.

Enhanced Depth Imaging with Ophthalmic Coherence Tomography was a milestone in imaging and introduced by the foundations leading investigators.
Koizumi H, Spaide R, Fisher Y, Freund B, Klancnik J, Yannuzzi L
Three-dimensional evaluation of vitreomacular traction and epiretinal membrane using spectral- domain optical coherence tomography. AM J Ophthalmol 143(3):509-517, 2008.

Brue C, Tseng J, Barbazetto I, Lima L, Yannuzzi L.
Peculiar manifestation of macular telangiectasia type 2. Retin Cases Brief Rep 5(4):309-312, 2011.

Rinaldi C, Vitale L, Pachydaki S, Yannuzzi L. Spontaneous resolution of macular schisis in Goldmann Favre Syndrome.Retin Cases Brief Rep 5(1):84-86, 2011.

Acute idiopathic maculopathy was a new disease discovered by investigators supported by the Macula Foundation. It resulted in an exudative detachment of the macula from a viral agent, from the Coxsachie virus.
Brue C, Barbazetto I, Markomichelakis N, Yannuzzi L, Freund KB, Kosolis A.
Atypical unilteralmaculopathy associated with exudative polymorphous vitelliformmaculopathy-like yellowish deposits. Retin Cases Brief Rep 6(2):135-8, 2012.

This comprehensive study of central serous chorioretinopathy described a bullous detachment of the retina, a rare but very devastating complication of the disorder.
Bullous variant of central serous chorioretinopathy: expansion of phenotypic features using multimethod imaging. Ophthalmology. April 12, 2016. [Epub ahead of print] pii:S0161-6420(16)00354-7. doi:10.1016/j.ophtha. 2016.03.017.PMID: 27021439. Ophthalmology 123(7)1541-1552, 2016.

Discovery of the pachychoroidal circulation was a major discovery by an investigator, supported by the Macula Foundation. It has been identified to be in association with a myriad of disorders, including central serous chorioretinopathy, age-related macular degeneration, including several of its variants.
Chung H, Byeon SH, Freund KB. Focal Choroidal excavation and its association with pachychoroid spectrum disorders: a review of literature and multimodal imaging findings. Retina doi:10.1097/IAE.00000000000001345. October 4, 2016. RETINA 37:199-221, 2017.
This is a correlation with multi modal technology and clinical-pathological findings. It is the result of analysis of a post mortem eye with Age-Related Macular Degeneration, retrieved by the Eye Bank for Sight Restoration and studied by Macula Foundation investigators to interpret the nature of the images and provide a better understanding of the abnormalities to develop future forms of treatment.
Chen, L., Messinger, J. D., Zhang, Y., Spaide, R. F., Freund, K. B., Curcio, C. A., 2020. Subretinal drusenoid deposit in age-related macular degeneration: histologic insights into initiation, progression to atrophy, and imaging. Retina 40, 618-631. PMID 31599795
The Macula Foundation, Inc.
210 E. 64th Street
New York, N.Y. 10065
(212) 605-3777
info@retinal-research.org